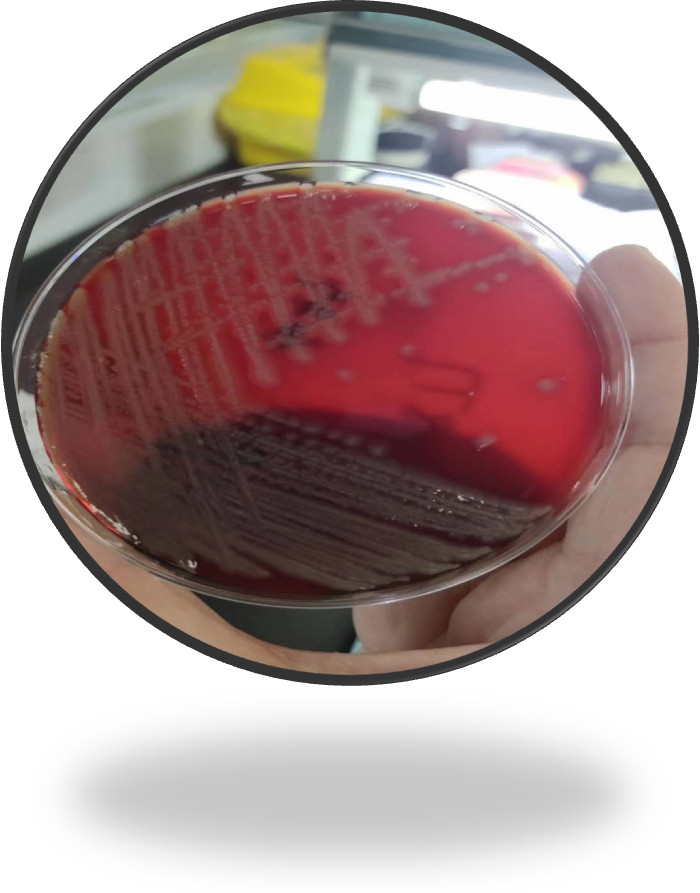
093) 2019.11.28 ▲血平板麦康凯平板培

铜绿假单胞菌血平板

图5 纯分光滑型菌落培养24h血琼脂平板上形态图6 纯分光滑型菌落培养
图片尺寸887x926
追踪痰中最常见的杀手之一铜绿假单胞菌
图片尺寸704x529
求助铜绿假单胞菌图谱
图片尺寸800x810
铜绿假单胞菌
图片尺寸307x234
橡皮糖你吃过,橡皮一样的铜绿你见过吗?
图片尺寸658x659
093) 2019.11.28 ▲血平板麦康凯平板培
图片尺寸700x893
铜绿假单胞菌感染
图片尺寸1387x1377
cn琼脂平板上铜绿假单胞菌和荧光假单胞菌的生长特征
图片尺寸1080x390
铜绿假单胞菌
图片尺寸345x200
铜绿假单胞菌
图片尺寸388x219
七彩山鸡养殖场铜绿假单胞菌的耐药性多位点序列分型及遗传进化分析
图片尺寸1575x1276
上述标本,细菌鉴定结果为铜绿假单胞菌,gram染色在显微镜(×1000)下
图片尺寸600x450
求助铜绿假单胞菌图谱
图片尺寸800x500
铜绿假单胞菌检验方法
图片尺寸1000x1000
一文了解铜绿假单胞菌
图片尺寸500x375
铜绿假单胞菌
图片尺寸366x211
铜绿假单胞菌
图片尺寸447x466
桶装水中铜绿假单胞菌检测及杀灭方法
图片尺寸500x457
食品中铜绿假单胞菌检测ppt
图片尺寸1080x810
铜绿假单胞菌感染的病因
图片尺寸347x350